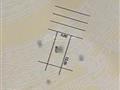

Bán đất đấu giá kiến hưng 60m2/5m mặt tiền phân lô vỉa hè được cpxd 7 tầng thang máy 12.5tỷ
1 / 4
- Mảnh đất cực đẹp thuộc khu đấu giá Kiến Hưng Hà Đông phân lô vỉa hè được caps phép xây dựng 7 tầng thang máy.
- Sổ đỏ 60m², 5m mặt tiền - giá rẻ nhất khu Kiến Hưng.
- 12.5 tỷ có thiện chí gia lộc.
- .
Xem thêm
Đặc Điểm
Loại Tin Rao: Đất Mặt Tiền
Giá: 12.5 tỷ
Diện Tích: 60 m2
Mặt Tiền: 5 mm
Mã Đăng Tin: 27020254
Ngày Đăng: 28/10/2025 - 11/11/2025
Xem quy hoạch của bđs tại Phường Kiến Hưng, Hà Đông, Hà Nội
Tin Đất Mặt Tiền Cùng Mức Giá Trong Phường Kiến Hưng, Hà Đông, Hà Nội
 Đang Tải ...
Đang Tải ...
Xem Bản Đồ